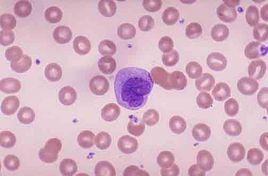
單核細胞(M,MONO) 單核細胞(M,MONO)

正常參考值
男:(4.0~5.5)×1012/L;
女:(3.5~5.0)×1012/L;
兒童:(3.5~4.7)×1012/L;
新生兒:(6.0~7.0)×1012/L。
臨床意義
生理性增多:
出生後兩周的嬰兒可呈生理性單核細胞增多。
病理性增多:
見於亞急性心內膜炎、瘧疾、黑熱病、急性感染恢復期、活動性肺結核等。
紅細胞(RBC)計數
增多:
(1) 相對性增多:見於大量脫水而致血液濃縮,如劇烈嘔吐、頻繁腹瀉、多汗、多尿、嚴重燒傷、長期不能進食等。
(2) 絕對性增多:見於嚴重的肺氣腫、肺原性心臟病、法魯四聯症、真性紅細胞增多症、慢性一氧化碳(CO2)中毒等。
(3) 生理原因:年齡與性別差異(如初生兒),長期多次獻血,缺氧刺激(如氣壓低、居住高原、劇烈體育活動等),精神因素(如感情衝動、冷水浴刺激)等,均可引起紅細胞增多。
減少:
(1)生理性貧血:見於6個月~2歲的嬰幼兒,妊娠中後期,某些老年人造血功能減退等。
(2)病理性貧血:見於貧血(如海洋性貧血、溶血性貧血、巨幼細胞貧血、營養性混合性貧血、鐵粒幼細胞貧血、再生障礙性貧血、急性失血性貧血)、白血病和骨髓增生異常綜合徵。
異常紅細胞
大小異常小紅細胞 增多多見於缺鐵性貧血
大紅細胞 增多多見於巨幼細胞貧血
巨紅細胞 增多可見於巨幼細胞貧血及肝臟疾病
形態異常球形紅細胞 常見於遺傳性球形細胞增多症、自身免疫性溶血性貧血、異常血紅蛋白病(如Hbs及Hbs病)
橢圓形紅細胞 明顯增多見於遺傳性橢圓細胞增多症(高於25%~50%才有診斷意義)、巨幼細胞貧血(可達25%)和惡性貧血,其他類型的貧血也可程度不同的增多
染色異常嗜多色性紅細胞 增多常見於增生性貧血,包括溶血性貧血、失血性貧血、巨幼細胞貧血、缺鐵性貧血等
結構異常染色質小體 染色質小體(Howell-Jolly’s小體)見於溶血性貧血、巨幼細胞貧血、惡性貧血、脾切除後等
染色質小體 卡波氏環(Cabot,s環)見於巨幼細胞貧血、溶血性貧血、惡性貧血、鉛中毒等;有核紅細胞見於溶血性貧血、急慢性白血病、原發性骨髓纖維化症、骨髓增生異常綜合徵、惡性腫瘤骨髓轉移、骨髓外造血及嚴重缺氧等